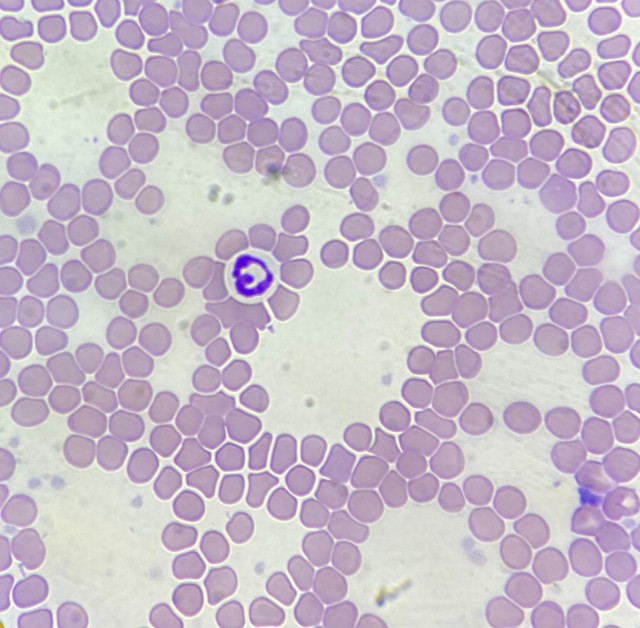
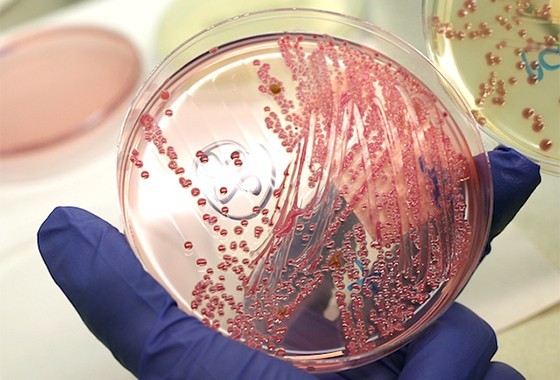

Tv. Bermudas, 77 Jardim Lindoia,
Porto Alegre - RS, CEP: 91.050-140
(51) 3023-4004
(51) 9674-8163
 /
/
 /
/